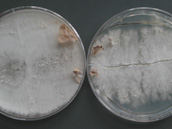

Associates
Chair
Prof. Oliver A. Cornely MD,
FACP, FIDSA, FAAM, FECMM, Cologne
Scientific Lead
Dr. Danila Seidel PhD,
Cologne
Project Manager
Natalia Vasenda MSc,
Cologne
Coordinating Physicians and Quality Control Team Cologne
Dr. Philipp Köhler MD
Dr. Jon Salmanton-García PhD
Dr. Rosanne Sprute MD
Dr. Jannik Stemler MD
Dr. Sibylle Mellinghoff MD
Stefanie Gräfe MD
Andrea Will
Epidemiology, IT & Statistics
Prof. J. Janne Vehreschild MD, FECMM, Cologne
Microbiology and Sample Storage
Dr. Hilmar Wisplinghoff MD,
Cologne
Molecular Identification
Dr. Volker Rickerts MD,
Berlin
Histopathology
Dr. Birgid Markiefka MD,
Cologne
Thoracic Surgery
Prof. Khosro Hekmat MD,
Cologne
Therapeutic Drug Monitoring
Dr. Carsten Müller MD,
Cologne
Impressum
J. Janne Vehreschild
Berrenrather Str. 196
50937 Köln
Tel: +49 221 478 85523
Email: janne.vehreschild@uk-koeln.de
Inhaltlich Verantwortlicher gemäß § 10 Absatz 3 MDStV:
Prof. Dr. med. Oliver A. Cornely
Haftungshinweis: Trotz sorgfältiger inhaltlicher Kontrolle übernehmen wir keine Haftung für die Inhalte externer Links. Für den Inhalt der verlinkten Seiten sind ausschließlich deren Betreiber verantwortlich.
Concept & implementation of site relaunch 2012
Sabine Reuter, Dipl.-Designerin
E-Mail, Website
Letztes Update: January 2018